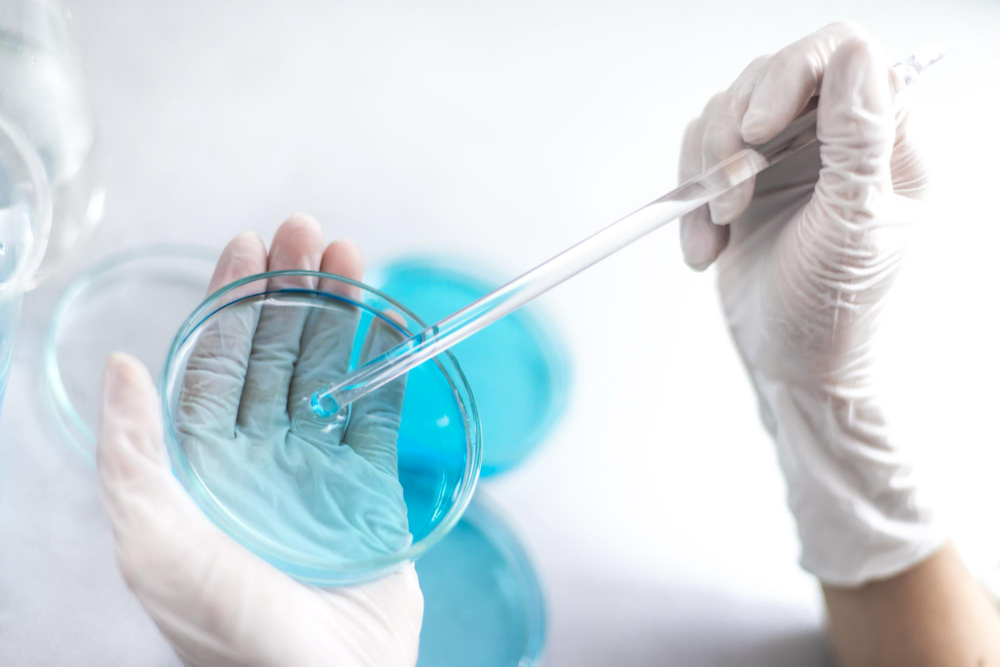
in-vitro-analizler-hayvansiz-test-metotlari-cruelty-free.jpg

Saniter, TS EN ISO/IEC 17025/ ISO IEC 17020 standartlarına uygun yapısıyla; kozmetik ürünlerin kalite, güvenlik ve mevzuata uygunluk süreçlerinde markalara tam kapsamlı test hizmetleri sunar.
Kozmetik ürünlerinde "hayvanlar üzerinde test edilmemiştir / cruelty-free, vegan" etiketi taşımak ve ürün güvenilirliğini artırmak için, Saniter tamamen hayvan testi içermeyen alternatif bilimsel yöntemlerle analizler yürütmektedir.Bu kapsamda gerçekleştirilen testler, uluslararası kabul görmüş OECD Test Rehberleri, ISO metotları, sitoloji ve moleküler analiz teknikleri ile desteklenmektedir.
Hizmet Kapsamı
1. Vegan- Cruelty Free Uygunluk Analizleri
Saniter, ürünlerin hayvansal içerik taşımadığını veya hayvansal DNA bulunmadığını doğrulamak için gelişmiş moleküler analizler kullanır.
1. In-Vitro (Hayvansız) Güvenlik ve Etkinlik Testleri
Saniter, hayvan testi gerektirmeden ürün güvenliğini doğrulayan in vitro alternatif test çözümleri sunar.
ISO 10993/ OECD Uyumlu Testler:
Cilt İrritasyon Testleri
Göz İrritasyonu Testleri
Cilt Korozyon Testleri
Fototoksisite Testleri
Sitotoksisite Testleri